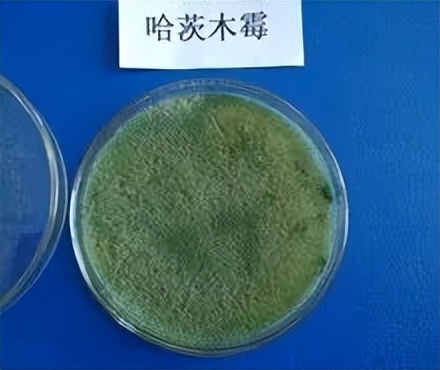

微生物杀菌剂
1、枯草芽孢杆菌
枯草芽孢杆菌主要通过竞争作用抑菌:在植物根际、体表或体内及土壤中快速、大量繁衍和定殖,有效地排斥、阻止和干扰病原微生物在植物上的定殖与侵染,从而达到抑菌和防病的效果。其次,枯草芽孢杆菌在生长过程中能产生多种具有抑菌、溶菌作用的物质,从而抑制病原菌的生长和繁殖,甚至破坏细菌结构,杀死病原菌。

枯草芽孢杆菌 图片来源:流浪天涯博客
枯草芽孢杆菌主要登记作物病害有:黄瓜白粉病、草莓白粉病和灰霉病、大白菜软腐病、柑橘溃疡病、水稻稻瘟病等,还可用于调节植物生长、诱导植物产生抗性,起到增强免疫和促进生长的作用。
枯草芽孢杆菌具体作用和使用方法可点击蓝字查看:《枯草芽孢杆菌的作用及使用注意事项》
2、木霉菌
木霉菌通过产生小分子的抗生素和大分子的抗菌蛋白或胞壁降解酶类来抑制病原菌的生长、繁殖和侵染;以及通过快速生长和繁殖而夺取水分和养分、占有空间、消耗氧气等,以至削弱和排除同一生境中的灰霉病病原物;木霉菌还会在特定环境里形成腐霉,对灰霉病菌具有重寄生作用,抑制葡萄灰霉病症状的出现。
木霉菌登记作物病害有:番茄灰霉病、黄瓜灰霉病和霜霉病、西瓜立枯病和青枯病、小麦纹枯病等。
3、哈茨木霉菌
哈茨木霉菌是木霉菌中应用的一个菌种,其主要有效成分为哈茨木霉菌T-22株系,通过在植物的根围、叶围迅速生长,抢占植物体表面的位点,形成一个保护罩,阻止病原真菌接触到植物根系及叶片表面,以此来保护植物根部、叶部免受上述病原菌的侵染,并保证植株能够健康地成长。同时也具有一般木霉菌的重寄生作用和抗生素作用。
哈茨木霉菌作为一种生防菌,可以用来预防由腐霉菌、立枯丝核菌、镰刀菌、黑根霉、柱孢霉、核盘菌、齐整小核菌等病原菌引起的植物病害;主要登记作物病害为番茄灰霉病和立枯病、猝倒病、葡萄霜霉病、人参灰霉病等。
4、荧光假单胞杆菌
荧光假单胞杆菌首先能够定殖于作物根际或根表,然后依靠产生的噬铁素或抗生素起作用;主要通过对铁离子的竞争——产生噬铁素络合根围铁离子,使病菌得不到足够的铁索营养,从而影响多种病原真菌的生长,减轻对植物体的危害;还可以产生多种抗生素,对病原菌有较强的杀伤作用。
荧光假单胞杆菌主要登记作物病害为:番茄青枯病、烟草青枯病、黄瓜靶斑病和灰霉病、水稻稻瘟病等。
5、解淀粉芽孢杆菌
解淀粉芽孢杆菌的作用机理主要包括分泌抗菌物质:产生低分子量抗生素以及抗菌蛋白或多肽等活性物质,抑制植物病原菌;产生拮抗作用:通过同化作用产生抗菌物质抑制有害病原物的生长或发展或直接杀灭病原物;营养与空间的竞争:迅速地抢占果蔬伤口的营养空间生长存活并大量繁殖,使得病原菌得不到合适的营养与空间条件而不能繁殖从而抑制病害的发生;并能诱导植物产生抗性。
解淀粉芽孢杆菌主要登记作物病害为:黄瓜角斑病、番茄枯萎病、西瓜枯萎病、烟草黑胫病和青枯病、水稻稻瘟病、纹枯病、细菌性条斑病等;并能产生赤霉素、吲哚乙酸、细胞分裂素等多种生理活性物质和氨基酸类物质,促进植物根系及植株生长。
植物源杀菌剂
1、小檗碱
小檗碱属于异喹啉类生物碱,对真菌性病害有显著的防治效果,主要是通过渗透作用干扰病原体的代谢而起到抑制生长和繁殖的作用;对细菌性病害也有一定的防效,可以破坏细菌表面结构,导致细胞内钙离子和钾离子外流,造成细菌内环境破坏,从而导致细菌生长被抑制。
小檗碱主要登记作物病害有:猕猴桃褐斑病、番茄灰霉病、辣椒疫霉病、柑橘青苔等。
2、香芹酚
香芹酚是一种绿色杀菌剂,能防止蔬菜和果树中的灰霉病,安全性好,无抗药性,并与多种植物源有效成分具有协同增效作用,是符合绿色农药生产标准的植物源活性成分。具体作用机理未见报道。
主要登记作物病害有:番茄灰霉病、猕猴桃灰霉病、枸杞白粉病、马铃薯晚疫病等。
3、大蒜素
大蒜素是成都新朝阳的专利植物源杀菌剂,主要防治细菌性病害,能够通过脂质氧化等作用改变病菌细胞膜特性,通过分子中的氧原子与细菌生长繁殖所必需的半胱氨酸分子中的琉基相结合,对菌体巯基酶形成竞争性抑制或使琉基酶失活,从而达到抑制细菌生长和繁殖的作用。
大蒜素抑菌原理
大蒜素主要登记作物病害为:甘蓝软腐病、黄瓜细菌性角斑病,对猕猴桃溃疡病、柑橘溃疡病等也具有较好的防效。
其他生物农药杀菌剂
1、氨基寡糖素
也称为农业专用壳聚糖,可改变土壤微生物区系, 促进有益微生物的生长而抑制一些植物病原菌。同时,壳寡糖对多种植物病原菌具有一定的直接抑制作用,通过影响真菌孢子萌发,诱发菌丝形态发生变异、孢内生化发生改变等;壳寡糖还可诱导植物的抗病性,激发植物体内基因,产生具有抗病作用的几丁酶、葡聚糖酶、保素及PR蛋白等,对多种真菌、细菌和病毒产生免疫和杀灭作用。
氨基寡糖素主要登记作物病害有:烟草病毒病、番茄病毒病、番茄晚疫病、棉花黄萎病水稻稻瘟病等; 并能活化细胞,刺激植物生长,有助于受害植株的恢复,促根壮苗,使农作物和水果蔬菜增产丰收。